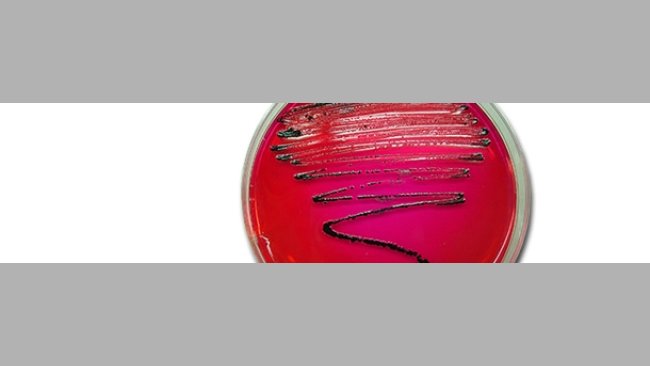

Observational study of farms with air filtering against the PRRS virus in North America
This study, based on some 120,000 sows, quantifies the reduction of the risk of introducing PRRS viruses when using air filtering.
The pig sector events all around the world
Weekly newsletter with all the pig333.com updates
Swine industry news in your email
Pig health: news and articles on PRRS, PCV2, biosecurity, etc, Pig disease guide, atlas of pathology, clinical cases…
Biocheck.UGent is an independent, risk-based, scientific scoring system for assessing the quality of your on-farm biosecurity.
A visual and practical step-by-step guide on how to perform a necropsy on a pig.
All the information about ASF: how to recognize the disease, how it is transmitted, pictures of lesions, latest news, guides, etc.
All the information on Foot and Mouth Disease in pigs: how to recognize the disease, how it is transmitted, images of lesions, latest news, guides,...
Description of the most important diseases and conditions in pigs
Images of major swine diseases
Pig disease diagnostic tool
Definition for the most commonly used pig terms
Simulator that calculates the amount of drug to add to the water when using a flow dispenser.
Weekly newsletter with all the pig333.com updates
Pig Prices by countries. Pork production and trade. News of the pig market and the raw materials
The latest slaughter pig prices in the most important pig markets. Check the evolution of the historical prices in charts and in several currencies.
Latest quotations for the main commodities used in pig feed. Historical graphs with the pig price and estimated feed price.
Figures & trends in pig numbers, pork production and pork trade.
Global production and trade data for the most important raw materials
Weekly newsletter with all the pig333.com updates
Articles on nutrition and pig feeding, characteristics of raw materials and additives for pig feed. Prices of raw materials
Latest quotations for the main commodities used in pig feed. Historical graphs with the pig price and estimated feed price.
Technical sheets of the main raw materials and additives used in swine feed. They include a comparison of nutritional values from various sources, product
Global production and trade data for the most important raw materials
Definition for the most commonly used pig terms
Use this tool to diagnose problems with the feed conversion ratio. Click on the flowchart or on the buttons within the text to navigate through the different parts of the tool.
A biweekly newsletter with the latest developments in swine nutrition
Articles on genetics and pig reproduction: genetic improvement, genomics, artificial insemination, use of hormones
Compare production data, calculate the number of sow, nursery, and finishing spaces, and visualize your tasks on the work schedule by type of BMS.
Tool that allows you to calculate the replacement rate in your farm
Definition for the most commonly used pig terms
Use this tool to find out why your farrowing rate is less than ideal. Click on the flowchart or on the buttons found within the text to navigate through the different parts of the tool.
Weekly newsletter with all the pig333.com updates
Management, pig farm management, work planning in each production stage: management in gestation, grow finish, batch farrowing
Compare production data, calculate the number of sow, nursery, and finishing spaces, and visualize your tasks on the work schedule by type of BMS.
Tool that allows you to calculate the replacement rate in your farm
Definition for the most commonly used pig terms
Weekly newsletter with all the pig333.com updates
Design of facilities and equipment for pig farms: building design, climate control, feeding systems, etc.
Biocheck.UGent is an independent, risk-based, scientific scoring system for assessing the quality of your on-farm biosecurity.
Environmental Footprint Calculator along the pork value chain.
Definition for the most commonly used pig terms
Simulator that calculates the amount of drug to add to the water when using a flow dispenser.
Use this tool to explore which slurry management strategy best fits your situation. Click on the flow chart or on the buttons within the text to navigate through the different parts of the tool.
Weekly newsletter with all the pig333.com updates

This study, based on some 120,000 sows, quantifies the reduction of the risk of introducing PRRS viruses when using air filtering.

After the banning of antibiotics as growth promoters, there was an increase in their total consumption due to the therapeutics treatments...

The European Commission is reviewing and consulting how antimicrobials are used in veterinary medicine following the release of their 12 point programme in 2011. Present and future situation of antimicrobial use in the European Community is analysed.

How do we determine clinical significance? One way is to evaluate how many individuals need to be treated in order to obtain one more favorable outcome. This is the concept behind Number Needed to Treat (NNT).

We analyze a real case, and we will check out how a partial analysis of the data can give place to erroneous conclusions.

It was developed in USA as a way to improve communication of what needed to be done to improve the chances of success in stabilizing and managing breeding herds.

The pig farm management team in charge of the post-weaned piglet nursery areas on these wean-to-finish sites has found serious problems with diarrhoea in recent batches of piglets arriving from the breeding farms.

Can we get to know if the behaviour, from the sanitary point of view, of a certain batch of animals during their growth stage is being correct? How can we achieve this?

In July 2010 a severe respiratory disease occurred in the farm: coughing in gilts, and coughing and depression in fatteners concomitantly to an increase of the mean stillborn and mummified piglet rate in a batch of sows.
The risk of contamination by Salmonella increases along the food chain, reaching its maximum in the abattoir. So, the abattoir is one of the points in which the actions carried out can be most effective.

A summary of current knowledge to address frequently asked questions from producers and practitioners on PCV2-associated reproductive disease.

The “normal” sporadic and unexplained abortion rate in pigs is approximately 1 to 2 % of pigs that are mated and achieve a pregnancy.

When exposed, the pigs get infected in less time than the length of the transportation and the waiting period (prior to the slaughter) in the abattoir.

Two species of Brachyspira are well-recognized pathogens of pigs: B pilosicoli and B. hyodysenteriae. Recently, dysentery-like disease has been reported in association with infection by strongly beta-hemolytic spirochetes which are not identified as B. hyodysenteriae.

Given the high prevalence of the infection due to the PCV2 and its presence in healthy and sick animals, the serological tests against this pathogen have been questioned as a diagnostic test.